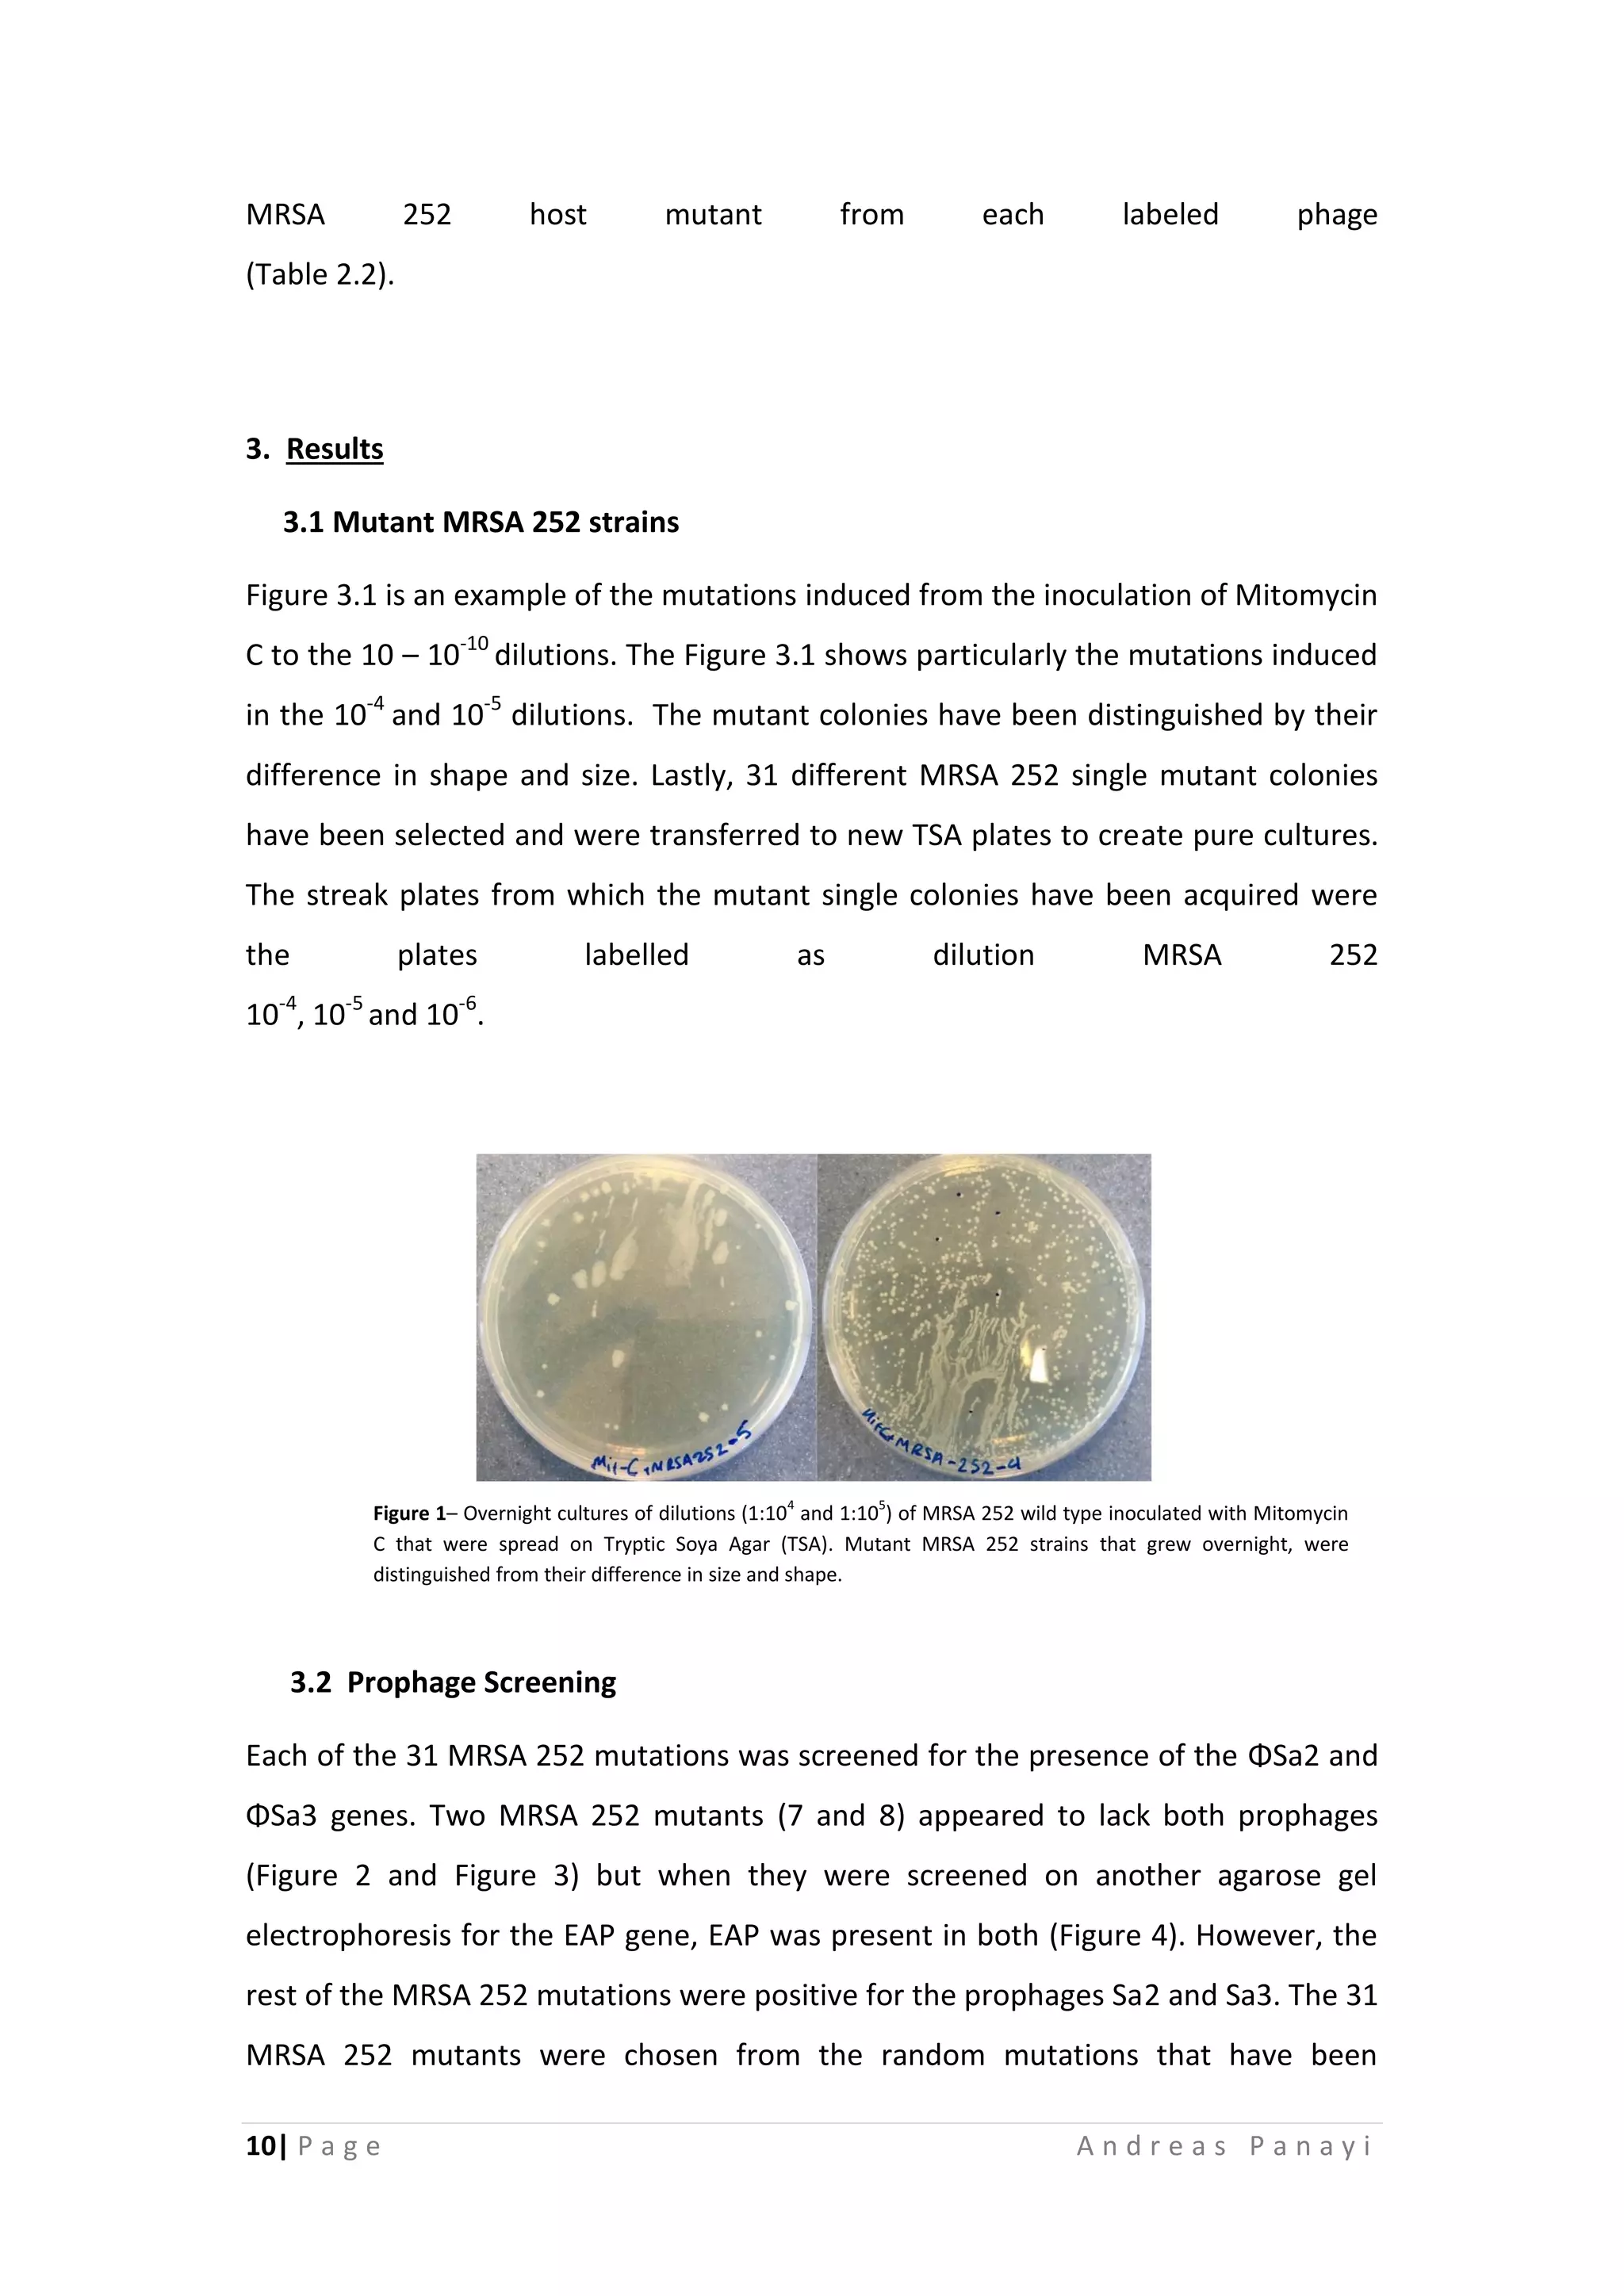
10| P a g e A n d r e a s P a n a y i
MRSA 252 host mutant from each labeled phage
(Table 2.2).
3. Results
3.1 Mutant MRSA 252 strains
Figure 3.1 is an example of the mutations induced from the inoculation of Mitomycin
C to the 10 – 10-10
dilutions. The Figure 3.1 shows particularly the mutations induced
in the 10-4
and 10-5
dilutions. The mutant colonies have been distinguished by their
difference in shape and size. Lastly, 31 different MRSA 252 single mutant colonies
have been selected and were transferred to new TSA plates to create pure cultures.
The streak plates from which the mutant single colonies have been acquired were
the plates labelled as dilution MRSA 252
10-4
, 10-5
and 10-6
.
3.2 Prophage Screening
Each of the 31 MRSA 252 mutations was screened for the presence of the ΦSa2 and
ΦSa3 genes. Two MRSA 252 mutants (7 and 8) appeared to lack both prophages
(Figure 2 and Figure 3) but when they were screened on another agarose gel
electrophoresis for the EAP gene, EAP was present in both (Figure 4). However, the
rest of the MRSA 252 mutations were positive for the prophages Sa2 and Sa3. The 31
MRSA 252 mutants were chosen from the random mutations that have been
Figure 1– Overnight cultures of dilutions (1:104
and 1:105
) of MRSA 252 wild type inoculated with Mitomycin
C that were spread on Tryptic Soya Agar (TSA). Mutant MRSA 252 strains that grew overnight, were
distinguished from their difference in size and shape.
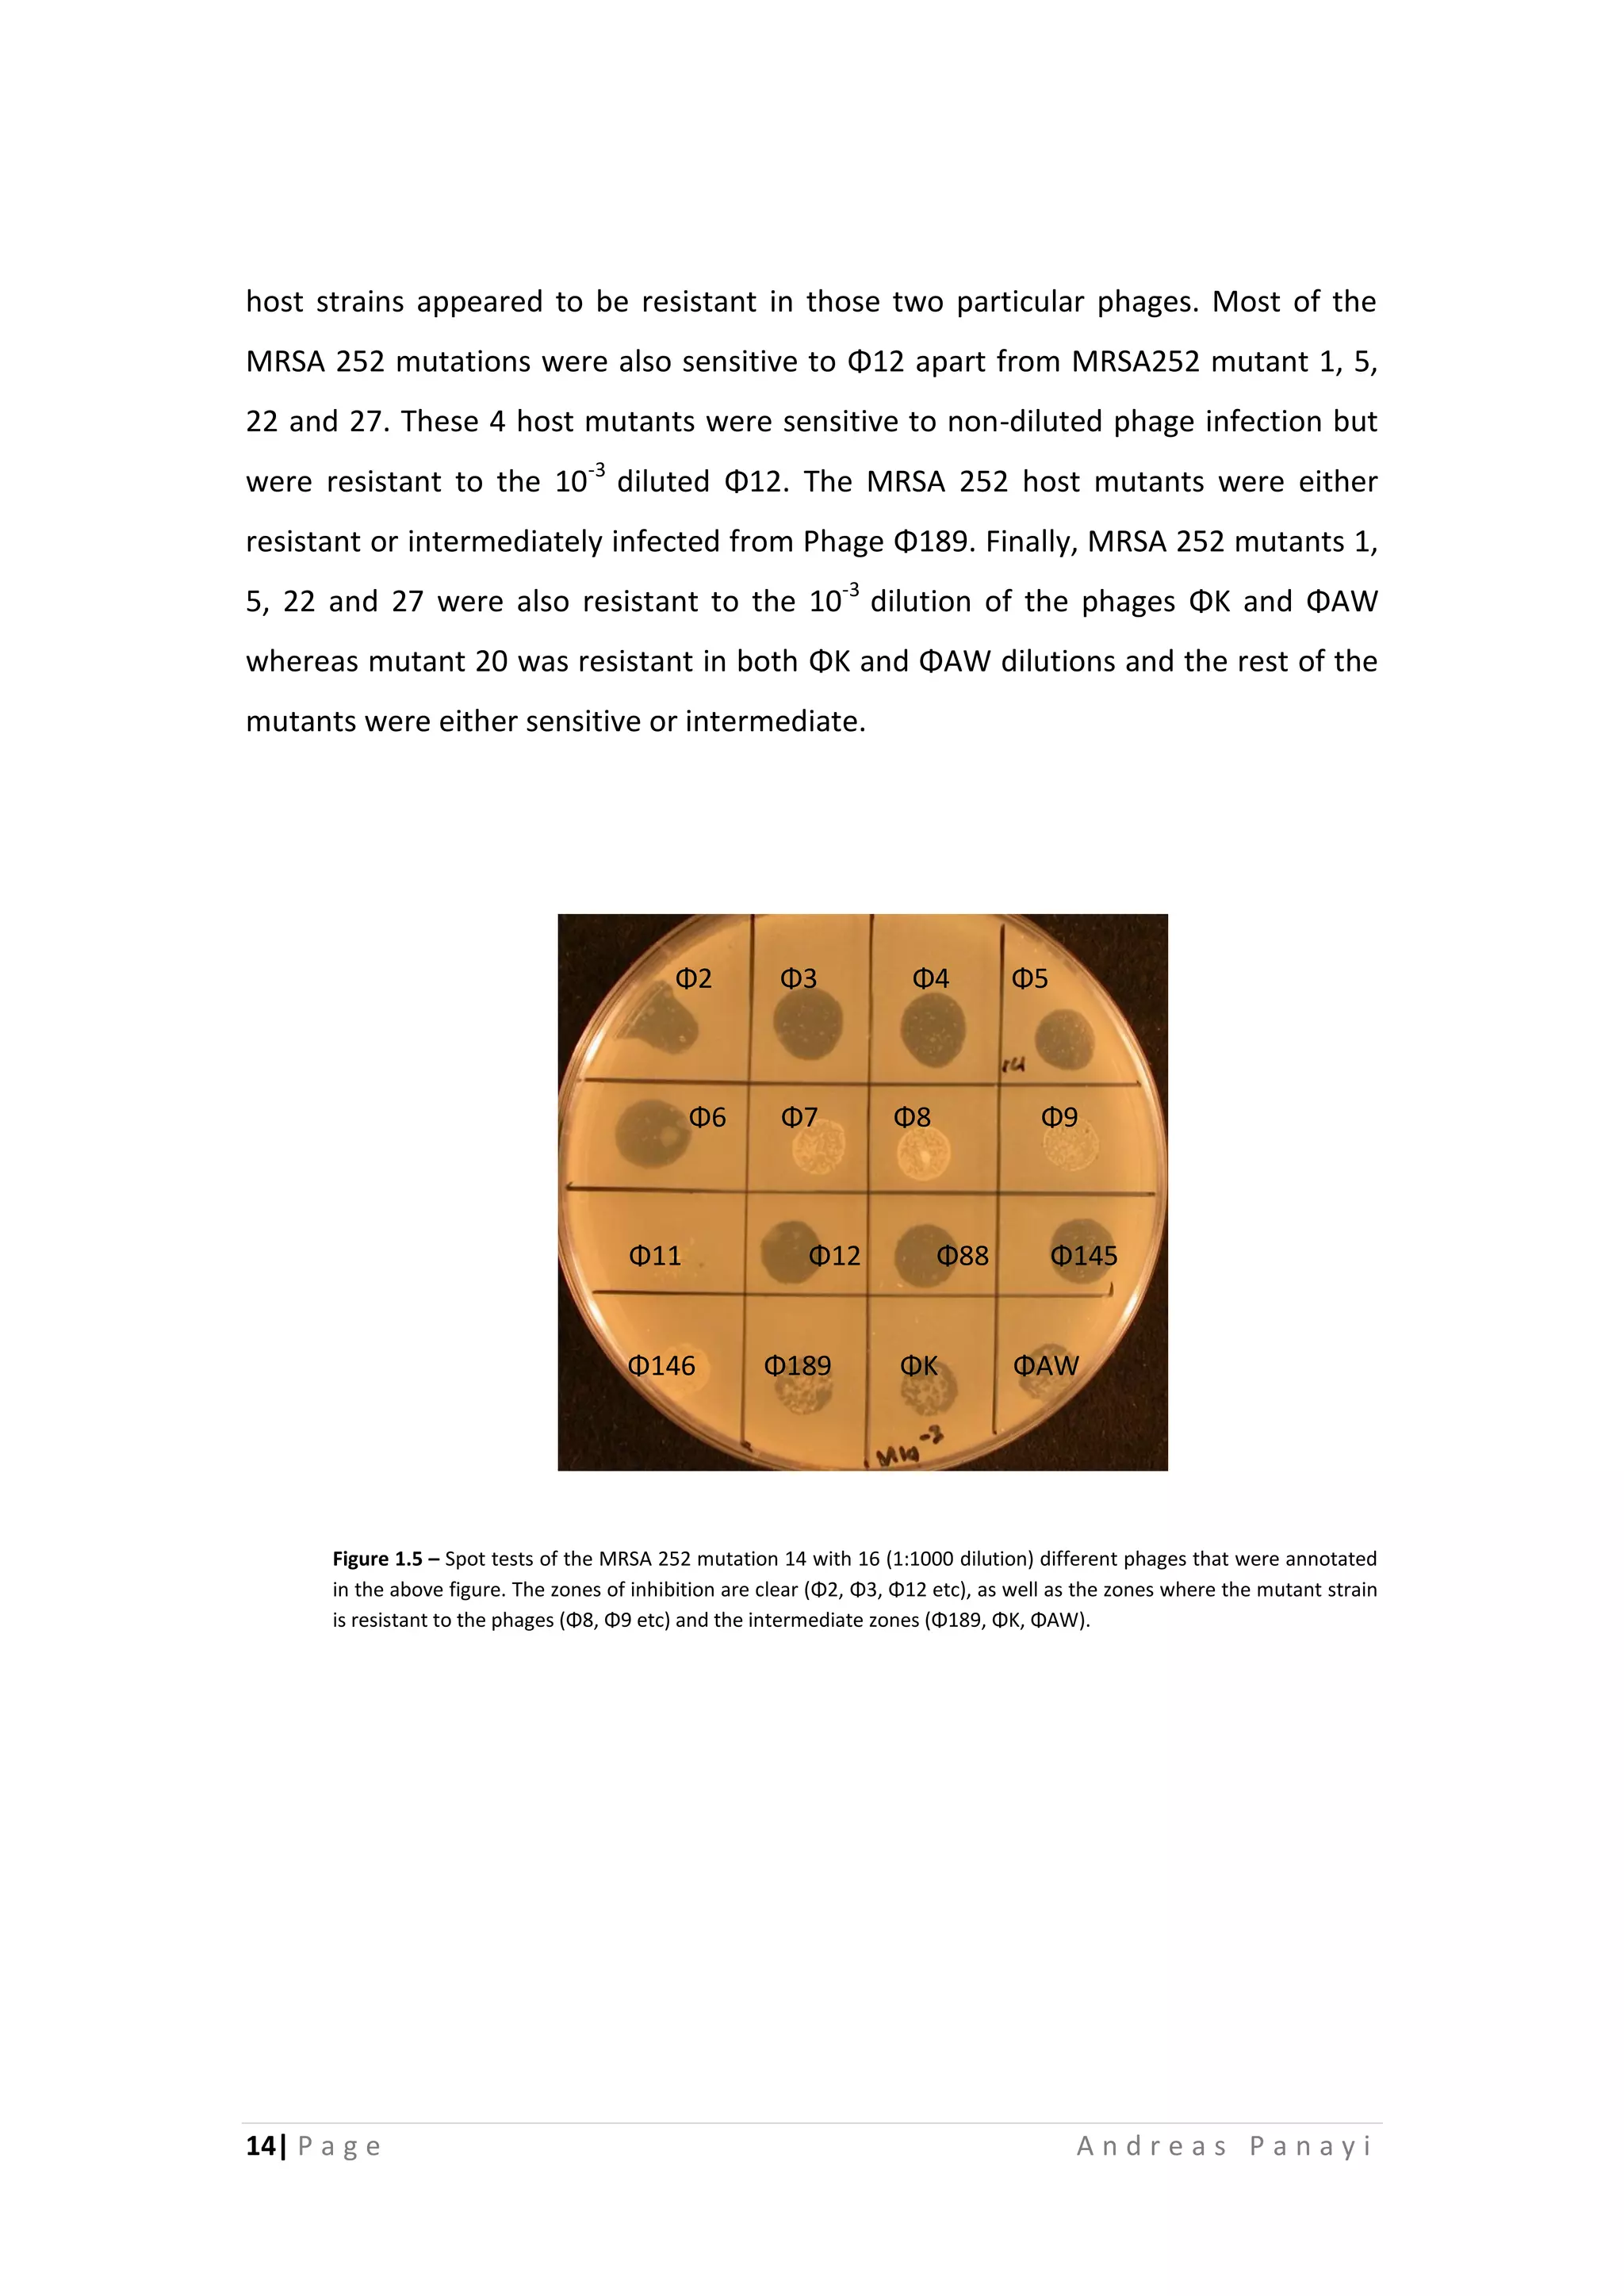
14| P a g e A n d r e a s P a n a y i
host strains appeared to be resistant in those two particular phages. Most of the
MRSA 252 mutations were also sensitive to Φ12 apart from MRSA252 mutant 1, 5,
22 and 27. These 4 host mutants were sensitive to non-diluted phage infection but
were resistant to the 10-3
diluted Φ12. The MRSA 252 host mutants were either
resistant or intermediately infected from Phage Φ189. Finally, MRSA 252 mutants 1,
5, 22 and 27 were also resistant to the 10-3
dilution of the phages ΦΚ and ΦΑW
whereas mutant 20 was resistant in both ΦΚ and ΦΑW dilutions and the rest of the
mutants were either sensitive or intermediate.
Figure 1.5 – Spot tests of the MRSA 252 mutation 14 with 16 (1:1000 dilution) different phages that were annotated
in the above figure. The zones of inhibition are clear (Φ2, Φ3, Φ12 etc), as well as the zones where the mutant strain
is resistant to the phages (Φ8, Φ9 etc) and the intermediate zones (Φ189, ΦΚ, ΦΑW).
Φ2 Φ3 Φ4 Φ5
Φ6 Φ7 Φ8 Φ9
Φ11 Φ12 Φ88 Φ145
Φ146 Φ189 ΦΚ ΦΑW

The document discusses a study on MRSA 252, a methicillin-resistant Staphylococcus aureus strain. It aims to construct a prophage-free host strain of MRSA 252 that can propagate lytic bacteriophages. 31 mutant strains of MRSA 252 were created using mitomycin C to induce prophages. Prophage screening using PCR found that mutations 7 and 8 did not contain the φSa2 and φSa3 prophages. Most mutant strains were susceptible to lytic phages in spot tests, but were resistant to some phages and high dilutions of others. Mutations 7 and 8 were resistant to all tested phages. The attempt to mobilize prophages from M









![8| P a g e A n d r e a s P a n a y i
2.4 Bacteriophage isolation
The phages that were used for the spot tests were isolated from raw sewage from
Davenhulme Sewage Treatment Works Manchester in 2015/16. A bacterial
enrichment protocol was followed in order to multiply the phages’ numbers. The
first step was to add 5 ml of overnight incubated in TSB actively growing S. aureus
cells in another TSB medium with 1 mM MgSO4 and 1 mM CaCl2 and re-incubate
overnight at 37°C. A 10-ml aliquot was taken from the overnight culture, and 1 M
NaCl and 0.2% chloroform were added. Centrifugation of the culture has later
followed at 3000 g of 30 minutes in order to remove the bacteria and the
supernatant was filtered-sterilized (0.22-m pore size; Millipore filter). The
supernatant, which was a lysate, was used to check if any lytic phages were present
using the double layer method. Isolated single plaques were picked into SM buffer
(5 M NaCl, 1 M MgSO4, 1 M Tris-HCl [pH 7.5], 0.01% (wt/vol) gelatin in distilled water
[dH2O]), and in order to obtain purified plaques, successive rounds of single plaque
purification have been performed until single plaques were formed. The purified
phages were stored in 50% (vol/vol) glycerol at 80°C for long-term use. Short-term
stock preparations were maintained at 4°C (Alves et al, 2014). The phages were
originally isolated on Staphylococcus aureus strain D390 which was isolated from the
nasal cavity of a healthy donor in Oxford, United Kingdom in 1998.
Loading buffer
Bromophenol blue
25mg
Ficoll 400 1.5mg
20μl dsH2O
Table 1.1 – Bromophenol blue and ficoll 400 mixed to make a
loading buffer for the agarose gel electrophoresis](https://image.slidesharecdn.com/009adbe4-862a-4d29-901e-1b430fe5a8df-161213180513/75/Final-year-project-10-2048.jpg)

![16| P a g e A n d r e a s P a n a y i
4. Discussion
4.1 Virulence factors of MRSA252
Staphylococcus aureus can commonly result in skin infections, respiratory diseases,
and food-poisoning, and the resistance that have emerged against antibiotics, such
as vancomycin and methicillin, becomes an issue in clinical medicine (Lim et al,
2015). The S. aureus isolates have several virulence factors and toxins such as
superantigens, Panton-Valentine leukocidins (PVL), exfoliative toxin type A,
staphylokinase, pathogenicity islands (SaPIs), genomic islands, chromosome
cassettes (SCC), transposons and conjugative plasmids. The MRSA 252, which is the
focus of this research, contains as showed in Figure 4.1 (Holden et al, 2004) below
some of those virulent factors, including SCC element, an integrated plasmid,
prophages Sa2 and Sa3. It also contains 4 genomic islands (νSaα, νSaβ, SaPI4 and
Tn916-like) and two transposons (Tn 554 and Tn552).
Figure 2 - Schematic circular diagrams of the MRSA252 chromosome. Where appropriate, categories are shown as pairs of
concentric circles representing the MRSA 252 strand. The outer colored segments on the gray outer ring represent genomic
islands and horizontally acquired DNA (see figure for key). Inside the gray outer ring, the rings from outside to inside
represent scale in Mbp, annotated CDS (colored according to predicted function), tRNA and rRNA (green), additional DNA
compared to the other S. aureus strain described here (MRSA252 where appropriate; red), additional DNA compared to other
sequenced S. aureus strains [N315 (5), Mu50 (5), and MW2 (6); blue], percentage of G + C content, and G + C deviation (>0%,
olive; <0%, purple). Color coding for CDSs is as follows: dark blue, pathogenicity/adaptation; black, energy metabolism; red,
information transfer; dark green, surface-associated; cyan, degradation of large molecules; magenta, degradation of small
molecules; yellow, central/intermediary metabolism; pale green, unknown; pale blue, regulators; orange, conserved
hypothetical; brown, pseudogenes; pink, phage plus insertion sequence elements; gray, miscellaneous (Holden et al, 2004).](https://image.slidesharecdn.com/009adbe4-862a-4d29-901e-1b430fe5a8df-161213180513/75/Final-year-project-18-2048.jpg)




![21| P a g e A n d r e a s P a n a y i
Potential Use as a Fomite Decontaminant.’ PLoS ONE. [Online] 10 (7). Available at:
http://journals.plos.org/plosone/article?id=10.1371/journal.pone.0131714
[Accessed: 11 March 2016].
7. Kazmierczak, Z. Gorski, A. Dabrowska, K. (2014) ‘Facing Antibiotic Resistance:
Staphylococcus aureus Phages as a Medical Tool.’ Viruses, 6 (7), pp. 2551-2570.
8. Kumar, N. G. P. Sundarrajan, S. Paul, D. V. Nandini, S. Saravanan, S. R. Harihanan,
S. Sriram, B. Padmanabhan, S. (2012) ‘Use of prophage free host for achieving
homogenous population of bacteriophages: New findings.’ Virus Research, 169
(1), pp. 182-187.
9. Lim, S. Lee, D. H. Kwak, W. Shin, H. Ku, H. J. Lee, J. E. Lee, G. E. Kim, H. Choi, S. H.
Ryu, S. Lee, J. H. (2015) ‘Comparative genomic analysis of Staphylococcus aureus
FORC_001 and S. aureus MRSA252 reveals the characteristics of antibiotic
resistance and virulence factors for human infection.’ Journal of Microbiology and
Biotechnology, 25 (1), pp. 90-108.
10. Lowy, F. D. (2003) ‘Antimicrobial resistance: the example of Staphylococcus
aureus.’ The Journal of Clinical Investigation, 111 (9), pp.1265-1273.
11. Manzana, C. (2012) ‘The induction, purification and host range of four lysogenic
staphylococcus aureus bacteriophages.’ Ph.D thesis, Baylor University, Texas.
12. Otto, M. (2012) ‘MRSA virulence and spread.’ Cellular microbiology, 14 (10), pp.
1513-1521.
13. Rahimi, F. Bouzari, M. Katouli, M. Pourshafie R. M. (2012) ‘Prophage and
antibiotic resistance profiles of methicillin-resistant Staphylococcus aureus strains
in Iran.’ Archives of Virology, 157 (9), pp. 1807-1811.
14. Rockney, A. Kobller, O. Amir, A. Court, L. D. Stavans, J. Adhya, S. Oppenhelm, B. A.
(2008) ‘Host responses influence on the induction of lambda prophage.’
Molecular Microbiology, 68 (1), pp. 29-36
15. Xia, G. Wolz, C. (2014) ‘Phages of Staphylococcus aureus and their impact on host
evolution.’ Infection, Genetics and Evolution: Journal of molecular epidemiology
and evolutionary genetics in infectious diseases, 21 (1), pp.593-601.](https://image.slidesharecdn.com/009adbe4-862a-4d29-901e-1b430fe5a8df-161213180513/75/Final-year-project-23-2048.jpg)